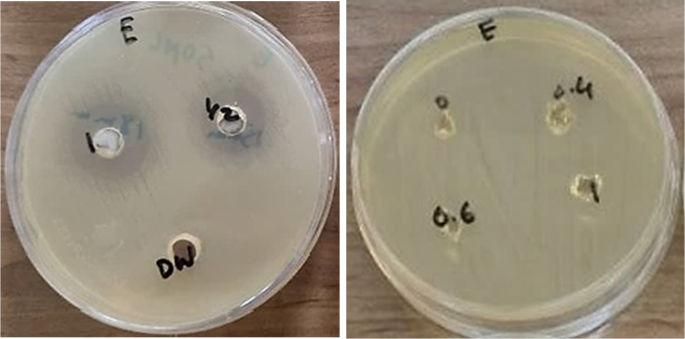
Fig. 13

Abstract
CMC/AAc/ZnO, a novel antimicrobial superabsorbent hydrogel, was prepared via the copolymerization of carboxymethyl cellulose (CMC) and acrylic acid (AAc) by incorporating zinc oxide nanoparticles through gamma radiation. The morphological and structural properties were investigated with the aid of characterization techniques such as scanning electron microscopy (SEM), Fourier-transform infrared (FT-IR), energy dispersive X-ray spectroscopy (EDX), X-ray diffraction (XRD), and thermogravimetric analysis (TGA) and Differential Scanning Calorimetry (DSC) analysis. In addition, the swelling behaviour analysis displayed superior pH-responsive performance in distilled water than in saline solutions. XRD confirmed that the ZnO nanoparticles were present in a crystalline state in the polymer matrix. EDX mapping was also used to study the elemental distribution of ZnO, carbon, and oxygen in the nanocomposite. TGA provided evidence of substantial thermal stability; hence, the strength of the material could be very efficient. Besides, the highly effective antibacterial property of CMC/AAc/ZnO against Escherichia coli is confirmed through different assays, such as leaching and nonleaching tests. Unlike conventional methods, this technique avoids the need for chemical crosslinkers or initiators, as gamma radiation induces polymerization and incorporation of the nanoparticles. The resulting nanocomposite exhibits better swelling capacity, thermal stability, and antibacterial activity against Escherichia coli. Such properties make it a promising and novel candidate for biomedical and environmental applications. This research emphasizes the great possibilities of using CMC/AAc/ZnO nanocomposite superabsorbent polymers for manifold biomedical applications and opens up new pathways in the growth of eco-friendly antibacterial material.
Similar content being viewed by others
Introduction
Superabsorbent polymers, also known as SAP, are a type of hydrophilic polymeric network structure that can absorb significant quantities of water. These polymers exhibit excellent water retention capabilities, maintaining their effectiveness even under elevated pressure or temperature1. The presence of ionic functional groups in the crosslinked polymer chains generally facilitates water flow within the network while preventing the substance’s dissolution in water2. SAPs are frequently employed in various uses, including agriculture, hygiene, cosmetics, food, and drug delivery3.
Superabsorbents with eco-friendly properties and biodegradability are finding increasing interest in the academic and industrial fields, appealing to the growing environmental consciousness and support for sustainable research practices4. The preparation of these superabsorbents exploits various natural polymers such as cellulose, starch, chitosan, alginate, carrageenan, and gellan gum5. Carboxymethylcellulose (CMC) is a cellulose derivative with anionic carboxymethyl ether, possessing tasteless, non-toxic, and water-soluble characteristics that render it suitable for potential use in various industrial sectors as a stabilizing, thickening, and binding agent. Its chemical reactivity and high hydrophilicity make it promising for applications in superabsorbent fields. The abundant –OH functional groups in CMC chains allow for easy modification through graft polymerization with hydrophilic vinyl monomers, resulting in new SAPs with enhanced properties. Ionizing radiation is an efficient method for producing SAPs due to its high energy levels, eliminating the need for initiators, catalysts, and crosslinkers in gamma radiation processing6. Radiation processing offers numerous benefits, including convenient process regulation and eco-friendliness due to the absence of residues or environmental contaminants7.
Inorganic metal oxide materials are a focus of interest within antibacterial materials owing to their wide-ranging inhibitory properties and potent bactericidal impact8,9. Zinc oxide nanoparticles (ZnO) have an established reputation for their powerful antibacterial properties, making them a key ingredient in various cosmetic products. ZnO nanoparticles are a type of inorganic metal oxide that display a broad range of nanostructures. In addition to their affordability and safety for in vitro use, the considerable antibacterial properties of ZnO nanoparticles make them an appealing alternative material, providing reassurance about their potential use in the nanocomposite10,11.
ZnO nanoparticles have shown excellent antibacterial properties and thus are potential candidates for biomedical and environmental uses. The antibacterial property of ZnO is mainly due to three significant mechanisms: the production of reactive oxygen species (ROS), direct contact with bacterial cell membranes, and the release of Zn²⁺ ions. ZnO nanoparticles can generate ROS, including hydroxyl radicals (·OH), superoxide anions (O₂·⁻), and hydrogen peroxide (H₂O₂), upon exposure to an aqueous medium or UV light. The ROS forms induce oxidative stress, causing lipid peroxidation, protein denaturation, and DNA damage, which finally cause the death of bacterial cells12,13. Due to their intensive surface charge, ZnO nanoparticles electrostatically attract negatively charged bacterial membranes. Interaction leads to disruption of membrane integrity, such that its permeability and cytoplasmic material leakage increase. Physical destruction of this kind compromises bacterial cells and exposes them to oxidative stress. ZnO is appropriate for releasing Zn²⁺ ions in water, which penetrate bacterial cells and interfere with the activities of essential enzymes. The ions inhibit metabolism, inhibit bacteria from cell division, and induce structural change in proteins and nucleic acids of the cells14. Significant advances in materials engineering and nanomaterials have recently led to the developing of highly effective multifunctional materials for biomedical and environmental applications. Researchers have explored the strategic design of advanced nanomaterials for removing heavy metals from wastewater, demonstrating their potential in environmental remediation and pollution control15. In addition, the growing menace of antimicrobial resistance has accelerated the development of novel biosensors and screening assays16, which enable the rapid detection of resistant bacterial strains and enhance the efficacy of antimicrobial medications. Recent studies have also highlighted the application of polyaniline-silver core-shell nanocomposites17 as high-performance electromagnetic shields, expanding the application of nanomaterials in protective and electronic coatings. Besides, borophene-based nanomaterials have also been established to be passable candidates for emerging applications in vapour and gas sensing18 due to their superb physicochemical properties.
Such developments provide an excellent foundation for high-performance nanocomposites based on ZnO with improved antibacterial activity, per the aim of this research work to present a green, high-performance antibacterial hydrogel for medical and environmental applications. Variations in the radiation source, radiation parameters, and acrylic acid solution concentrations have been observed in prior research. These factors play a significant role in determining the structure and, consequently, the swelling behaviour of the hydrogels produced. Limited research, however, has been conducted on the swelling behaviour of CMC/AAc/ZnO nanocomposites. This work developed a nanocomposite comprising acrylic acid, zinc oxide, and CMC through the copolymerization process of acrylic acid with CMC and incorporating zinc oxide nanoparticles through gamma radiation. The hydrogels were assessed based on the amount of gel they contained and their swelling characteristics.
Experimental
Material
CMC was obtained from Sigma-Aldrich Company with a purity of 99.5%. AAc with a purity of 99.5%, sodium hydroxide with an 84% concentration, and sodium chloride (NaOH), were procured from Merck Company. The acrylic acid was stored in a refrigerator until utilization. Sodium hydroxide was utilized to neutralize the reaction medium. Nanosany Company manufactured the zinc oxide nanoparticles (ZnO, 99% 10–30 nm) that were acquired. Distilled water was employed and fertilized for polymerization. The analytical grade of each reagent was utilized without purification.
Methods
Preparation of CMC/AAc
CMC (0.5, 1, 2% wt.) was stirred with distilled water in a beaker for an hour at room temperature. Then, partially neutralized acrylic acid (15%) using NaOH. The mixture was poured into glass test tubes and sealed. Finally, it was irradiated by γ-rays with 5, 10, 15, and 20 kGy doses at room temperature (~ 27 ºC). The CMC/AAc SAP obtained in a cylindrical shape was cut into small pieces and dried.
Preparation of CMC/AAc/ZnO
A series of solutions with a neutralization percentage of 0.75 were created. These solutions contained 0.5 CMC and 15% AAc. Then, zinc oxide nanoparticles were added to the combination described before to create solutions that included 0.4, 0.6, 0.8, and 1% zinc oxide. After the mixture was put into glass test tubes, it was sealed and subjected to γ-rays at 27 °C. The gamma radiation dose was 20 KGy. After sufficiently drying, the cylindrical CMC/AAc/ZnO SAP was divided into small pieces and then crushed. This process was carried out with great care. The hydrogel samples before and after the drying process are shown in Fig. 1.
Hydrogel samples before and after the drying process.
Characterization
Different methods were used to analyze the CMC/AAc/ZnO nanocomposite superabsorbent polymer for physical, chemical, and antibacterial characteristics. Free swelling capacity was analyzed based on the tea bag method in deionized water and saline based on the swelling of the hydrogels. The swelling of the hydrogels was tracked by observing the amount of weight they gained in different liquids and at various times. The study showed that the hydrogels can respond to pH changes. In addition, determining gel fraction measured the stability of hydrogel networks by determining weight changes before and after immersion in distilled water. Surface morphology has been reported by SEM (Zeiss, Model-EVO18), EDX and Mapp (Oxford) indicating structural characteristics of hydrogels as a function of ZnO incorporation. Fourier-transform infrared spectroscopy (Tensor 27 model from Bruker, Germany) confirmed chemical interaction within the polymer matrix by identifying functional groups and shifts indicative of successful copolymerization. Energy-dispersive X-ray spectroscopy (All gamma radiation with a batch system, using cobalt-60 gamma radiation of the gamma cell type at room temperature) analyzed the nanocomposite for its elemental composition, confirming the presence of zinc, carbon, and oxygen. The XRD (Philips, model pw1730, Netherlands) showed the crystalline nature of ZnO nanoparticles embedded in the polymer-hence, which resulted in successful integration. TGA and DCS (TA, model, Q600, America) confirmed the thermal stability by showing the weight loss profile at various temperatures, obtaining information about the degradation behavior. Finally, the antimicrobial tests were performed using leaching and non-leaching methods against Escherichia coli, showing tremendous antibacterial activity with ZnO nanoparticles. All gamma radiations were conducted with a batch system, utilizing a cobalt-60 gamma irradiator of the gamma cell type at ambient temperature.
Free swelling capacity (FSC)
A free absorption measurement test in deionized water and a physiological serum solution (0.9% sodium chloride solution) was used to measure swelling using the tea bag method. 0.1 g (W1) of superabsorbent in 500 g of deionized water (or saline water 0.9%) was placed for half an hour until the sample reached equilibrium swelling. Then, the bag was removed from the liquid, the excess liquid was removed by hanging the bag for 2 min, and the bag was weighed (W2). The same steps were followed for the bag without the sample to serve as blank, and it was also weighed (W0). Absorption capacity or equilibrium swelling (g/g) was calculated from the following equation:
The pH media was prepared by diluting standard HCl (1.0 M) and NaOH (1.0 M) solutions with distilled water to achieve the desired acidic and basic pH levels, respectively.
Swelling behavior
Hydrogel samples must first be made. Hydrogel samples that have been dehydrated must be used for this. Drying them in a vacuum oven or letting them air dry until their weight stabilizes can guarantee this. Record each hydrogel’s initial dry weight using an analytical balance. This is crucial since it will serve as the foundation for the swelling computation.Then, hydrogel samples were placed in a beaker or a petri dish containing a swelling medium. Carefully ensure that hydrogels were covered entirely with medium; this was distilled water. Hydrogels were allowed to swell for periods. Hydrogels must be allowed to swell without interference. The usual measurement of swelling was measured at every one h interval for 6 h or until equilibrium was attained.
We carefully removed the hydrogel samples from the swelling medium, using tweezers or forceps, at each time point. Remove excess water from the surface of the hydrogels using filter paper or tissue by blotting it carefully without squeezing, which may affect the result. The swollen hydrogel was immediately weighed in the analytical balance after removing surface water to get the swollen weight. Return the hydrogel to the swelling medium for further measurements if needed. This is repeated at intervals until swelling has stabilized, where the hydrogel reaches maximum absorption, customarily marked by no further weight increase. To calculate the swelling ratio of each hydrogel sample, we used the following formula:
Ws is the weight of swollen hydrogel at a given time after water absorption, and Wd is the dry weight of the hydrogel at the beginning. This equation provides the swelling capacity in percent and represents the amount of water taken up by the hydrogel in terms of its weight in the dry state.
Determination of gel fraction
After being dried until a constant weight (W0), the SAP specimens were submerged in distilled water for 24 h. Subsequently, they were taken out from the distilled water and dried until reaching a constant weight (W1) using a vacuum oven. The gel fraction was determined through the following calculation:
Where W1 is the weight of the dry sample after extraction in water, and Wi is the initial weight of the dry sample.
Well-diffusion method for antibacterial assay
Antibacterial properties of pure ZnO nanoparticles and CMC/AAc/ZnO nanocomposites were assayed on Escherichia coli ATCC 25,922 by a well-diffusion method. This well-diffusion method involves inoculating bacteria onto agar plates and making wells to introduce tested substances. In this experiment, the substances would be introduced inside the agar in wells to test the materials’ leaching and non-leaching antibacterial behaviours.
The procedure was initiated with a fresh culture of Escherichia coli in a suitable growth medium. When the desired concentration was attained, it was evenly spread on the Plate Count Agar (PCA) plates to obtain equal bacterial growth. Under complete sterile conditions, wells were punched into the agar surface at specific positions, and in those wells, ZnO nanoparticles, CMC/AAc/ZnO nanocomposite, and CMC/AAc hydrogel were placed. The wells had proper labelling to identify the samples, and distilled water was used as a negative control. The samples were pipetted out carefully into the wells. Plates were incubated at 37 °C after filling in for 24–48 h to achieve bacterial growth and elution of antibacterial agents from the wells to the agar. Following incubation, bacterial inhibition zones around the wells were looked for. These inhibition zones reflect areas where bacterial growth was interfered with by the antibacterial agents present within the samples. In this respect, the diameter of the ZOI was measured to find the extent of bacterial inhibition; hence, the complete indication of the antibacterial efficiency for each material was attained. A comparison of antibacterial activity by different samples was made to underline the role of ZnO nanoparticles and their interaction in the hydrogel matrix in antibacterial performance.
Leaching antibacterial assay
Assuming that the antibacterial substance is of the leaching antibacterial material, the antibacterial activity of CMC/AAc/ZnO superabsorbent was evaluated using the well-diffusion method according to the CLSI M2-A8 (2003) method. The culture (18 h) of E. coli ATCC 25,922 in Soybean Casein Digest broth was adjusted to 1.5 × 108 CFU/mL, comparable to 0.5 turbidity on the McFarland scale, and seeded onto Petri dishes with Plate Count Agar (PCA). Wells with a diameter of 6 mm were created, and the bottoms of the wells were blocked with sterile agar. Then, 50 mg/mL of CMC/AAc/ZnO with 0.4, 0.6, and 1% ZnO was aseptically swollen in wells with sterile distilled water. ZnO nanoparticles with 1% concentration were suspended in sterile phosphate buffer saline (PBS pH = 7.2) and dispersed by sonication to yield a uniform colloidal suspension concentration with concentrations of 0.5 and 1 mg/mL. The plates were incubated at 37 oC for 18 h. Zones of inhibition (ZOI) around the wells, which indicate bacterial growth inhibition due to the antibacterial substance’s absorption into the agar, were measured and photographed11.
Non-leaching antibacterial assay
Studies were conducted to further explore the efficacy of the antibacterial substance as a non-leaching antibacterial material, following the guidelines of ASTM E2149-13a (American Society for Testing and Materials) under dynamic conditions. Specifically, a working inoculum of 50 ± 0.1 mL was prepared, containing around 9.3 × 108 cfu/L of E. coli ATCC 25,922 in a 0.3 mM KH2PO4 pH = 7.2 buffer, which was then incubated with 100 mg of CMC/AAc/ZnO hydrogel with 1% ZnO. After an hour of vigorous shaking at 300 rpm, the viable bacterial count in the suspension was assessed following serial dilution in PBS and subsequent pour plating on PCA. The agar plates were then incubated at 37 ± 1 °C for 18 h for microbial growth. The resulting colonies were enumerated as Colony Forming Units (CFU) and adjusted by the dilution factor to determine the total microbial count in the suspension. The percentage reduction (R) was calculated by comparing the log10 CFU of sample B (CMC/AA hydrogel) to that of sample A (CMC/AAc/ZnO hydrogel) using the formula:
A flask containing KH2PO4 buffer with E. coli ATCC 25,922 load was used as an inoculum-only sample to assess the antibacterial properties of the control gel (CMC/AAc)19,20.
Results and discussions
The current investigation utilized gamma radiation to synthesize hydrogels by employing a water-soluble, biodegradable polymer (CMC) in combination with the AAc monomer. AAc was specifically chosen for its carboxylic group, which makes it the ideal option to facilitate the formation of an interpenetrating network with CMC. Upon exposure to gamma radiation, the aqueous solution of CMC and AAc undergoes radio decomposition of water due to the presence of hydrated electrons, hydroxyl, and hydrogen radicals. The hydroxyl radical (·OH) extracts a hydrogen atom from CMC, forming CMC macroradicals. Gamma radiation cleaves the vinyl group in AAc, generating a saturated bond and AAc radical21. The CMC/AAc hydrogel crosslinking network is formed by crosslinking CMC macroradicals and AA radicals22. Beforeradiation, ZnO nanoparticles are introduced into CMC/AAc solutions to create CMC/AAc/ZnO nanocomposites hydrogel.
FT-IR spectra analysis
The FT-IR spectrum in Fig. 2 illustrates the distinctive characteristics of pure CMC powder and CMC/AAc hydrogel. The neatCMC exhibited absorption bands corresponding to O–H stretching at 3461 cm− 1, intramolecular and intermolecular hydrogen bonds in cellulose, –CH2– stretching on hydroglucose units at 2922 cm− 1, C = O carbonyl stretching in the hydroglucose unit of the cellulose at 1642 cm− 1, C–OH in in-plane bending at 1418 cm− 1, –OH bending vibration at 1322 cm− 1, C = O stretching from an asymmetric oxygen bridge at 1157 cm− 1, and ring stretching at 905 cm− 1. These findings align with the results reported by Rim Dusit et al.23 and Wang et al.24 As depicted in Fig. 2, the distinctive absorption bands of CMC at 1064 and 1157 cm− 1 were diminished after the reaction in the CMC/AAc composite hydrogel. In the spectrum (Fig. 2b), the band at 1728 cm− 1 (C = O stretch of –CO2H groups) depicted the C = O stretch of the carbonyl group of acrylic acid that was not present in Fig. 2a. The band shifted towards a less obvious wavenumber at 1629 cm− 1 for CMC/AAc SAP (1642 cm− 1 for CMC). The findings also suggest that AAc monomers were attached to the CMC backbone. A new absorption peak in the CMC/AA/ZnO SAP appears at 452 cm− 1 due to ZnO nanoparticles being incorporated into the gel matrix (Fig. 2c)25.
FTIR spectrum of CMC powder (a), CMC/AAc (b), and CMC/AAc/ZnO (c).
XRD analysis
XRD pattern in Fig. 3, curve a, is broad with peaks observed around 7.13° and 22.1° (2θ). The broadness of the peaks shows the amorphous nature of the hydrogel. In amorphous materials, the crystalline structure is not well ordered. Such is typical for polymeric hydrogels, including CMC/AAc, since they are constituted by polymer chains that are arranged randomly. The peak at 22.1° may indicate the presence of some organized regions, but the general pattern indicates a mostly amorphous material. When ZnO is added in CMC/AAc hydrogel, curve b, the XRD pattern shows apparent differences. The sharp peaks are observed at around 18.2° and 22.1° and a minor peak around 7.2° (2θ). The sharp peaks at 18.2° and 22.1° indicate a crystalline structure within this hydrogel due to the presence of ZnO nanoparticles. ZnO is known as a crystalline material, and the addition of ZnO in the hydrogel matrix is most likely responsible for the crystallinity observed. The analogy of the peak at 22.1° in patterns (a) and (b) would suggest that this peak may correspond to the contribution of CMC/AAc hydrogel. However, the sharp peak at 18.2° in the CMC/AAc/ZnO pattern points to the extreme contribution of ZnO towards crystallinity in this composite. These interactions with ZnO may intentionally alter the physical properties, such as the hydrogels’ mechanical strength and swelling behavior.
XRD curves of CMC/AAc (a) and CMC/AAc/ZnO (b).
Gel fraction of SAP
Gamma radiation was applied to the gel fraction of the CMC/AAc blend at several dosages, and the results of this experiment are depicted in Fig. 4 as changes in the amount of CMC present in the feed solution. According to the statistics on the gel fraction, the formation of the negligible gel would occur at five kGy. When the radiation dose is increased from 5 to 10 kGy, the gel fraction of CMC/AAc with varying concentrations of CMC increases. The gel fraction reaches its highest value when the radiation dose is increased to 15 kGy. When gamma rays make contact with CMC and AAc in an aqueous solution of CMC/AAc, free radicals are generated on both of these substances. A graft copolymer consisting of CMC and AAc is ultimately produced due to the ensuing random reactions involving these radicals. When the gamma radiation dose reaches a particular threshold, the polymer chains undergo an accelerated crosslinking process, forming a substance similar to gel. It has been found that there is a minor rise in gel fraction as the concentration of CMC increases. This is because CMC is present, which results in an increased number of crosslinking occurrences.
Gamma radiation dose and CMC concentration influence the gel fraction of CMC/AAc (with 5% error bar).
Swelling behaviour
The swelling behaviour of the CMC/AAc hydrogel to the CMC/AAc/ZnO hydrogel, represented by Fig. 5, enables the acquisition of some helpful information about the interaction between the polymer network and water, including the role of ZnO in modifying the swelling properties. First, in the case of the CMC/AAc hydrogel, there is a fair increase in swelling up to about 1100% after 6 h. This can be considered the typical behaviour of a hydrophilic polymer network, such as that formed by combining CMC and AAc. The presence of carboxymethyl groups in CMC and carboxylic groups in AAc can form hydrogen bonds with water molecules. The relatively moderate crosslinking density of the network imparts a relatively gradual rate of swelling. The lower swelling percentage of the CMC/AAc hydrogel structure, without any extra crosslinking agents or fillers, indicates that it can only absorb a limited amount of water.
However, the CMC/AAc/ZnO hydrogel has another trend: the increase in its swelling percentage is speedy, reaching 2600 to 2700% within the first 3 h, and then it levels off. The addition of ZnO nanoparticles significantly enhances the water-absorbed capacity of the hydrogel. This probably occurs because ZnO nanoparticles behave as physical crosslinkers in the hydrogel network, increasing its porosity and making more sites available for hydrogen bonding with water. The presence of ZnO introduces stronger interactions between the polymer chains and water because nanoparticles can form hydrogen bonds with carboxyl groups of CMC and AAc.
This enhanced interaction thus leads to a higher swelling rate and a high improvement of percentage equilibrium swelling compared to the CMC/AAc hydrogel without ZnO. The plateau in the swelling behaviour after 3 h shows that the CMC/AAc/ZnO hydrogel reaches its maximum swelling capacity long before that for the unmodified hydrogel. The balance of the elastic force of the network and water absorption forces forbids further swelling in this stage. This behaviour underlines ZnO’s ability to significantly alter the hydrogel’s structure and performance. This indicates that the network of CMC/AAc/ZnO hydrogel is more open and porous; hence, it is a better candidate for applications involving high water retention or fast swelling, such as in drug delivery, wound healing, or some other environmental applications like water purification.
Swelling behaviour of CMC/AAc hydrogel (a) and CMC/AAc/ZnO hydrogel (b) over 6 h.
The radiation dose and CMC concentration on the absorption of CMC/AAc in water and saline
Figure 6a illustrates the impact of radiation dose and CMC concentration on the absorption of CMC/AAc in water, while Fig. 6b depicts the same for saline solution. The results indicate that at all CMC concentrations, the samples’ gamma radiation with doses ranging from 5 to 10 kGy enhances the absorption of water and saline solutions by the SAPs. The observed result can be increased crosslinking density with higher gamma radiation doses. A reduction in swelling is noted with increased crosslinking after 10 kGy, as there is diminished unoccupied space within the crosslinking network for the free solvent to infiltrate. In the solution containing 0.5% CMC, an enhancement in the absorption of water and salt solution is noted across all absorbed doses; the recorded water and salt absorptions are 437 and 76 g/g, respectively, at a dose of 20 kGy, suggesting that at this low concentration of CMC, acrylic acid predominates as the principal component that polymerizes and crosslinks in an aqueous medium.
Gamma radiation dose and CMC concentration influence the absorption of CMC/AAc in water (a) and saline (b) (with 5% error bars).
The effect of ZnO addition on the swelling impact of CMC/AAc in water and saline solution was studied (Fig. 7). It was found that the water absorption of SAP does not change significantly with the addition of ZnO nanoparticles up to 0.8% ZnO. In comparison, it decreases at 1% ZnO. Different behaviour is observed in saline solution. With the increase in the amount of ZnO, the swelling increases. The presence of positively charged ZnO nanoparticles could increase the influx of water molecules to counteract the accumulation of ion osmotic pressure, consequently resulting in the expansion of the hydrogel26,27. Additionally, the presence of ZnO nanoparticles within the hydrogel matrix leads to the expansion of the network, increasing both the size of the pores and the amount of free spaces available. This, in turn, enhances the water adsorption capacity of the hydrogel network28.
Swelling behaviour of CMC/AAc/ZnO prepared with 0.5% CMC at 20 kGy (with 1% error bars).
Effect of pH on swelling behavior of CMC/AAc/ZnO
The pH sensitivity of the CMC/AAc/ZnO hydrogel with 0.5% CMC and 1% ZnO was investigated by studying the swelling behaviour of the hydrogels in the pH range of 2 to 10. Figure 8 shows the fascinating behaviour of CMC/AAc/ZnO nanocomposite hydrogels at different pH levels. These hydrogels, formulated with 0.5% CMC and 1% ZnO, demonstrate remarkable sensitivity to pH variations, as evidenced by their swelling capacity. The findings emphasize the profound effect of pH on the swelling behaviour of hydrogels, casting light on their possible roles in drug release systems and water retention in plants in agriculture, where the surrounding pH may change significantly. Specifically, the hydrogels manifest less swelling at lower pH, which is explained by the reduced electrostatic repulsion among the polymer chains. On the other hand, the hydrogels demonstrate higher swelling at higher pH, which becomes evident due to the enhanced repulsive interactions in the hydrogel system. The reliability of the findings is reinforced by the 5% error bars in the graph, underlining the potential of these nanocomposite hydrogels for responsive swelling in varying pH environments. Finally, the swelling of all hydrogels increased as the pH rose from 2 to 7, but it decreased at higher pH values (pH > 7). The pH shift from 2 to 7 triggers the conversion of carboxyl groups on the CMC chains into negatively charged carboxylate ions, ultimately boosting electrostatic repulsion and enhancing water absorption29. An elevation in the ionic strength of the solution under pH conditions above 7 reduced the degree of swelling.
Swelling attribute of CMC/AAc/ZnO (0.5% CMC and 1% ZnO) hydrogels at diverse pH levels (with 5% error bars).
SEM analysis
CMC and AAC were analyzed through scanning electron microscopy (SEM) in Fig. 9, which showed a distinctively rough surface morphology with uneven textures and particles of different shapes. The roughness increases the surface area, improving adhesion, absorption, etc., making the material suitable for application areas needing highly interactive surfaces. It is seen that the addition of ZnO results in considerable modification in the surface morphology of CMC/AAC matrix. It sometimes causes an increased surface roughness due to aggregation of the nanoparticles, which may lead to additional layering of structures on the surface. The higher roughness can forecast higher mechanical interlocking, which enhances the super swell capability of the composite to absorb more water along with swelling. Alternatively, ZnO can introduce a specific homogeneous phase into the nanoparticles’ composite to seal the voids between polymer chains. A smoother surface can decrease resistance and enhance flow properties, which can be helpful in applications involving loading medicine or coating preparation.
SEM micrographs of CMC/AAc (a) and CMC/AAc/ZnO superabsorbent (b).
EDX analysis
Figure 10 displays two EDS spectra for superabsorbent materials: carboxymethylcellulose/AAc (a) and CMC/AAc/ZnO (b). Spectrum (a) is primarily carbon (43.07%) and oxygen (44.38%), with some sodium (12.55%). Spectrum (b) introduces zinc (4.22%) and shows a slightly modified composition, with carbon (42.32%), oxygen (37.30%), and increased sodium (16.16%). The addition of zinc in the spectrum (b) suggests potential improvements in properties such as antimicrobial effects or structural integrity. These spectra illustrate the elemental disparities between the two formulations, emphasizing the impact of zinc on the superabsorbent’s characteristics.
EDX spectrum of CMC/AAc (a) and CMC/AAc/ZnO superabsorbent (b).
Mapping analysis
In Fig. 11a, CMC/AAc, the elemental mapping signals the presence of carbon, C; oxygen, O; and sodium, Na. The distribution of carbon and oxygen is as expected since AAc was used to give the main chain in the hydrogel matrix, carboxymethyl cellulose, CMC, and acrylic acid. These polymers are rich in carbon from their organic nature and contain oxygen from the carboxyl, -CO2H, and ether, -O-, functional groups. The green map of sodium (Na) probably comes from Na-CMC. The sodium ions in Na-CMC neutralize the carboxylate groups (–CO2−); hence, the hydrogel forms in a stable way. From this SEM image of the sample, one could guess that the surface is porous and somewhat rough, features typical of hydrogels, allowing water penetration and swelling. The visible aggregated structure corresponds to a network capable of holding large volumes of water, reinforcing its role as a superabsorbent material.
Figure 11b shows increased complexity due to adding ZnO nanoparticles. From the elemental mapping, the presence of Zn is noticed besides the other atoms, namely carbon, oxygen, and sodium. Accordingly, it can be shown that ZnO nanoparticles are well dispersed within the polymer matrix. As the yellow map points out, ZnO is essential for reinforcing the mechanical properties of the hydrogel. It is clear that the oxygen here does not come only from the polymer chains but likely also reflects oxygen from the ZnO particles. Compared to pure CMC/AAc, the SEM photograph of this composite shows more complexity in surface morphology; moreover, rod-like and irregular particles stand out, probably due to ZnO. In this respect, ZnO can improve various functions such as thermal stability, mechanical properties, or antimicrobial/photocatalytic activities.
Mapping images of CMC/AAc (a) and CMC/AAc/ZnO superabsorbent (b).
TGA analysis
The data from TGA and DSC are in Fig. 12. provide helpful information on the temperature effect on the CMC/AAc hydrogel and the CMC/AAc/ZnO composite hydrogel. The CMC/AAc hydrogel depicts the expected profile of multi-step weight loss in a TGA analysis (Fig. 12a). The initial weight loss, up to 100–150 °C, corresponds to water evaporation, free and loosely bound within the hydrogel structure. This characterizes hydrogels with high water content because of their superabsorbent nature. The significant decomposition of the polymer network, within the increasing temperature up to 200–400 °C, is where a significant weight loss occurs due to breaking the carboxyl and hydroxyl groups of the CMC and AAc, respectively. In this stage of degradation, the polymer backbone is degraded, and volatile small organic molecules are formed. Above 400 °C, the residue is minimal due to the nearly complete thermal decomposition of the organic part of the hydrogel.
Thermal transitions in TGA/DSC analysis provided additional details on the decomposition processes of CMC/AAc, as presented in Fig. 12b. Endothermic peaks in the DSC curve, continuing to approximately 150 °C, corroborate the water loss process in this range. This is consistent with the dehydration stage uncovered in the TGA data. Exothermic peaks between 200 and 400 °C are visible as temperature increases, indicative of polymer matrix degradation. Such exotherms indicate the breaking of chemical bonds in the CMC and AAc constituents; energy is liberated as the polymer oxidizes and disintegrates thereafter. Beyond this value, the DSC curve levels off to indicate that all significant thermal events have occurred and only minimal residual ash remains, which agrees with the minimum residue indicated by the TGA curve. When ZnO nanoparticles are introduced into the hydrogel matrix (Fig. 12c), its thermal behaviour changes notably. In the case of CMC/AAc/ZnO, the first step of weight loss due to water evaporation remains the same, up to 150 °C. However, the presence of ZnO modifies the thermal decomposition behaviour of the polymer network. Most probably, ZnO nanoparticles act as a stabilizing agent, shifting the beginning of the main decomposition phase to 200–400 °C. The ZnO thus improves the thermal stability of this composite since it can absorb and scatter heat more effectively, reducing the rate at which the polymer degrades. This is manifested in its reduced rate of weight loss compared to pure CMC/AAc hydrogel. Following the degradation of organic parts in the hydrogel, a significant residual mass remains from the ZnO, which at these temperature ranges does not degrade into further volatile products.
Analogously, TGA-DSC of CMC/AAc/ZnO (Fig. 12d) provides further information on the thermal transitions of the composite: the endothermic peaks concerning the water loss are still present, although broader or slightly shifted concerning the pure hydrogel due to the interaction of water molecules with ZnO. These are followed by exothermic peaks between 200 and 400 °C corresponding to the polymer degradation, which, compared to the pure hydrogel, appeared with less intensity, reflecting the action of thermal stabilization by ZnO. The presence of ZnO suppresses the intensity of those exothermic events, probably resulting in a more controlled degradation process. Once the decomposition is complete, the DSC curve stabilizes, and the residue consists mainly of ZnO without further thermal events.
TGA analysis of CMC/AAc (a) TGA/DSC analysis of CMC/AAc (b) TGA analysis of CMC/AAc/ZnO (c), and TGA/DSC analysis of CMC/AAc/ZnO (d).
Antibacterial assay
Environmental products release active antibacterial substances. These substances disrupt essential biological structures or metabolic processes to exert their antimicrobial effect. Surface-active or polymer-bound additives, however, exert their effect only on the material’s surface by physical interaction with bacterial structures30. Leaching and non-leaching behaviour were performed to investigate the antibacterial mechanism of CMC/AAc/ZnO. The well-diffusion method was used for all samples to study the leaching behaviour. Around the well containing ZnO, a remarkable ZOI was observed, which indicated the antibacterial properties of the nanoparticle, which was spread onto the agar surface. Despite the significant swelling of the CMC/AAc/ZnO samples in the wells, no ZOI was observed around the wells. Figure 13 showcases the potent antibacterial properties of ZnO nanoparticles and the CMC/AAc/ZnO nanocomposite against Escherichia coli ATCC 25,922 on Plate Count Agar (PCA). The left panel highlights the impressive antibacterial efficacy of ZnO nanoparticles, as evidenced by the clear zone of inhibition around the wells where the nanoparticles were applied. This demonstrates the inherent antibacterial power of ZnO, effectively hindering the growth of E. coli.
In contrast, the right panel presents the remarkable antibacterial activity of the CMC/AAc/ZnO nanocomposite, manifesting a significantly larger zone of inhibition than ZnO alone. This heightened antibacterial performance suggests that integrating ZnO into the CMC/AAc matrix not only preserves the antibacterial properties of the nanoparticles but also amplifies the overall antibacterial effectiveness of the composite material. These compelling results accentuate the potential of the CMC/AAc/ZnO nanocomposite for use in biomedical applications, particularly in developing antimicrobial coatings and wound dressings, where robust bacterial inhibition is critical for infection prevention. The findings also underscore the pivotal role of the composite structure in optimizing the antibacterial impact of ZnO nanoparticles.
Antibacterial activity of ZnO nanoparticles (left) and CMC/AAc/ZnO (right) to E. coli ATCC 25,922 on PCA.
By not observing ZOI, the possibility of ZnO binding to the hydrogel was given. In this way, the dynamic method was investigated.
Figure 14 effectively showcases the potent antibacterial activity of the dynamic method using the CMC/AAc/ZnO nanocomposite against Escherichia coli ATCC 25,922. The findings unequivocally display a noteworthy reduction in bacterial count when the E. coli suspension comes into contact with the CMC/AAc/ZnO hydrogel containing 1% ZnO nanoparticles. As shown in Fig. 8, a 61.8% reduction in the log10 microbial count was observed when exposed to CMC/AA/ZnO compared to CMC/AA with a 53.8% reduction. This substantial reduction in viable E. coli cells demonstrates the potent antibacterial properties imparted by incorporating ZnO nanoparticles into the hydrogel matrix. The dynamic method employed in this study provides a more realistic assessment of the antibacterial performance under agitated conditions, simulating real-world applications where the hydrogel may encounter bacterial contamination. The results highlight the potential of the CMC/AAc/ZnO nanocomposite for use in biomedical applications, such as wound dressings and antimicrobial coatings, where effective bacterial inhibition is crucial.
Antibacterial activity of CMC/AAc/ZnO to E. coli ATCC 25,922 in a dynamic method.
Comparison studies
This comprehensive study in Table 1 puts into keen perspective the significance of our CMC/AAc/ZnO nanocomposite research as a significant advancement in developing antibacterial superabsorbent polymers. Our research, relative to previous works that mostly applied chemical crosslinking agents, focuses on green chemistry through gamma radiation crosslinking, thus avoiding the possibility of toxicity and still maintaining excellent material performance. Whereas existing literature has explored either superabsorbency or antibacterial activity but not both, our work, for the first time, demonstrates dual-functionality through leaching and non-leaching antibacterial activities against E. coli with high swelling capacity. Our systematic methodology for characterizing the work enables us to identify fundamental structure-property correlations not hitherto investigated in the literature, particularly those relating to the nano-crystalline character of ZnO and how they affect polymer performance. Our findings extend beyond incremental improvement to establish gamma radiation as a potential platform technology for future-generation functional biomaterials. This positions our research at the nexus of materials science, environmental sustainability, and antimicrobial technology-addressing urgent global needs for high-performance materials with reduced environmental impact.
Further suggestions
The other areas that could be pursued to enhance the practical utility of the material are optimization of the synthesis parameters, stability tests for a longer time, and evaluation of the biodegradability of the CMC/AAc/ZnO nanocomposite. More precise information about the value of this nanocomposite material will be acquired by studying, on a molecular level, such aspects as the swelling process and the antibacterial activity, with its possible application in agriculture and environmental cleanup. All these aspects are of prime importance to be considered for translating this research into real-world applications that are effective and environmentally sustainable: comparative analysis with existing superabsorbent materials, scalability regarding commercial production, and response to regulatory concerns regarding the safety of ZnO nanoparticles.
Conclusion
These research works on the superabsorbent polymer composites involving CMC/AAc/ZnO nanocomposite have produced valuable knowledge concerning the synthesis, characterization, and prospectuses of usage for these compounds. Thanks to such studies, there was verification that zinc oxide nanoparticles could successfully be incorporated into a carboxymethyl cellulose and acrylic acid matrix. This was done through a gamma radiation crosslinking process, which enhanced the antibacterial performance of the material without needing chemical initiators and crosslinkers. The resulting nanocomposite had an acceptable swelling characteristic, particularly against distilled water, with a pH response. This plays a crucial part in applications requiring different acidities in media. The structural and morphological information of the hydrogels was obtained using characterization methods such as TGA, SEM, FT-IR, X-ray diffraction, etc. The incorporation of ZnO was influenced by surface morphology based on scanning electron microscopy (SEM). FT-IR also verified the existence of functional groups responsible for the performance of the hydrogel. This proved that the copolymerization process was successful. In a polymer matrix, the XRD analysis results indicated that ZnO has a nano-crystalline character, proving its improved properties. Using leaching and non-leaching assays, the antibacterial properties of CMC/AAc/ZnO nanocomposite were evaluated thoroughly to understand its activity against Escherichia coli. Released antibacterial substances from hydrogel diffused in an agar medium resulted in detecting of large-sized inhibitory zones when tested in a laboratory leaching test. However, an experiment involving no leaching proved that the hydrogel has direct contact with bacteria, thereby preventing the bacteria from growing. These results substantiate the nanocomposite with dual properties whereby it can perform as both a superabsorbent and active antibacterial agent. Besides improving the hydrogel’s swelling capacity and heat resistance, incorporating ZnO nanoparticles into the polymer network also caused the hydrogel to exhibit significant antibacterial activity against Escherichia coli.
Introducing such a new window is an excellent opportunity to investigate and integrate superabsorbent polymers that are sustainable, high-performance, and exhibit high antibacterial activity. The application of CMC/AAc/ZnO nanocomposite in various biological applications, agricultural products, and sanitary products also has tremendous potential. Future research may optimize synthesis and further functionalization to achieve higher performance. Gamma radiation is a new method of polymer synthesis, and it stresses that it is safe. Its application is one of the potential methods to overcome the contemporary issues of antibacterial materials and environmentally friendly processes.
Data availability
All data have been given in the article.
References
Sarreshtehdar Aslaheh, H., Poursattar Marjani, A. & Gozali Balkanloo, P. Pelargonium as a cost-effective additive in bio-composite adsorbent in removing dyes from wastewater: Equilibrium, kinetic, and thermodynamic studies. J. Polym. Environ. 31, 3230–3247 (2023).
Raju, K. M., Raju, M. P. & Mohan, Y. M. Synthesis of superabsorbent copolymers as water manageable materials. Polym. Int. 52, 768–772 (2003).
Zhang, J. et al. Bilayer hydrogel with protective film and regenerative hydrogel for effective diabetic wounds treatment. Biomater. Sci. 12, 5036–5051 (2024).
Hien, N. Q., Van Phu, D., Duy, N. N. & Huy, H. T. Radiation grafting of acrylic acid onto partially deacetylated Chitin for metal ion adsorbent. Nucl. Instrum. Methods Phys. Res. B 236, 606–610 (2005).
Pérez-Álvarez, L., Ruiz-Rubio, L., Lizundia, E. & Vilas-Vilela, J. L. Polysaccharide-based superabsorbents: synthesis, properties, and applications. In: (ed Mondal, M.) Cellulose-Based Superabsorbent Hydrogels. Polymers and Polymeric Composites: A Reference Series. (Springer, 2019). https://doi.org/10.1007/978-3-319-77830-3_46
Zanbili, F., Gozali Balkanloo, P. & Poursattar Marjani, A. Semi-IPN polysaccharide-based hydrogels for effective removal of heavy metal ions and dyes from wastewater: A comprehensive investigation of performance and adsorption mechanism. Rev. Environ. Health https://doi.org/10.1515/reveh-2024-0004 (2024).
Nozad, E., Poursattar Marjani, A. & Mahmoudian, M. A novel and facile semi-IPN system in fabrication of solvent resistant nano-filtration membranes for effective separation of dye contamination in water and organic solvents. Sep. Purif. Technol. 282, 120121 (2021).
Asadzadeh, F. et al. Assessing polylactic acid nanofibers with cellulose and Chitosan nanocapsules loaded with chamomile extract for treating gram-negative infections. Sci. Rep. 14, 22336 (2024).
Li, J. et al. Balancing bacteria–osteoblast competition through selective physical puncture and biofunctionalization of ZnO/polydopamine/arginine-glycine-aspartic acid-cysteine nanorods. ACS Nano 11, 11250–11263 (2017).
Rasoulpoor, K., Poursattar Marjani, A. & Nozad, E. Competitive chemisorption and physisorption processes of a walnut shell based semi-IPN bio-composite adsorbent for lead ion removal from water: Equilibrium, kinetic and thermodynamic studies. Environ. Technol. Innov. 20, 101133 (2020).
Pal, K., Banthia, A. K. & Majumdar, D. K. Preparation of novel pH-sensitive hydrogels of carboxymethyl cellulose acrylates: A comparative study. Manuf. Mater. Process 21, 877–882 (2006).
Chaudhary, V. et al. Biogenic green metal nano systems as efficient anti-cancer agents. Environ. Res. 229, 115933 (2023).
Singh, K. et al. Defect and heterostructure engineering assisted S-scheme Nb2O5 nanosystems-based solutions for environmental pollution and energy conversion. Adv. Colloid Interface Sci. 332, 103273 (2024).
Pathania, D. et al. Essential oil derived biosynthesis of metallic nanoparticles: Implementations above essence. Sustain. Mater. Technol. 30, e00352 (2021).
Sable, H., Kumar, V., Singh, V., Rustagi, S., Chahal, S. & Chaudhary, V. Strategically engineering advanced nanomaterials for heavy-metal remediation from wastewater. Coord. Chem. Rev. 518, 216079 (2024).
Singh, N. V., Kasana, N. E., Batra, N. J., Sable, N. H. & Saxena, N. R. Antimicrobial resistance: Mechanisms, screening techniques and biosensors. J. Pharm. Negat. 13, 1724–1735 (2022).
Chaudhary, V. High performance X-band electromagnetic shields based on methyl-orange assisted polyaniline-silver core-shell nanocomposites. Polym.-Plast. Technol. Mater. 60, 1547–1556 (2021).
Chaudhary, V. et al. Borophene-based nanomaterials: Promising candidates for next-generation gas/vapor chemiresistors. J. Mater. Sci. 218, 236–262 (2024).
Campos, M. D., Zucchi, P. C., Phung, A., Leonard, S. N. & Hirsch, E. B. The activity of antimicrobial surfaces varies by testing protocol utilized. PLoS ONE 11, e0160728 (2016).
Saraswathy, M. et al. Bactericidal activity of superabsorbent polymer granules for their applications in respiratory fluid solidification systems. ACS Omega 8, 25114–25121 (2023).
Salmawi, K. M. E., El-Naggar, A. A. & Ibrahim, S. M. Gamma irradiation synthesis of carboxymethyl cellulose/acrylic acid/clay superabsorbent hydrogel. Adv. Polym. Technol. 37, 515–521 (2016).
Bhuyan, M. M. et al. Synthesis of potato starch-acrylic-acid hydrogels by gamma radiation and their application in dye adsorption. Int. J. Polym. Sci. 20, 1–11 (2016).
Rimdusit, S., Jingjid, S., Damrongsakkul, S., Tiptipakorn, S. & Takeichi, T. Biodegradability and property characterizations of methyl cellulose: Effect of nanocompositing and chemical crosslinking. Carbohydr. Polym. 72, 444–455 (2008).
Wang, X. L., Yang, K. K., Wang, Y. Z., Wang, D. Y. & Yang, Z. Crystallization and morphology of a novel biodegradable polymer system: Poly(1,4-dioxan-2-one)/starch blends. Acta Mater. 52, 4899–4905 (2004).
Elshahawy, M. F., Ahmed, N. A., Gad, Y. H. & Ali, A. E. H. Efficient photocatalytic remediation of lerui acid brilliant blue dye using radiation-prepared carboxymethyl cellulose/acrylic acid hydrogel supported by ZnO@Ag. Int. J. Biol. Macromol. 262, 129946 (2024).
Xiang, Y. & Chen, D. Preparation of a novel pH-responsive silver nanoparticle/poly(HEMA–PEGMA–MAA) composite hydrogel. Eur. Polym. J. 43, 4178–4187 (2007).
Li, Q. et al. A universal strategy for constructing hydrogel assemblies enabled by PAA hydrogel adhesive. Small 20, 2403844 (2024).
Jayaramudu, T., Raghavendra, G. M., Varaprasad, K., Sadiku, R. & Raju, K. M. Development of novel biodegradable Au nanocomposite hydrogels based on wheat: For inactivation of bacteria. Carbohydr. Polym. 92, 2193–2200 (2012).
Ma, X. et al. A low-swelling alginate hydrogel with antibacterial hemostatic and radical scavenging properties for open wound healing. Biomed. Mater. Res. 19, 065010 (2024).
(a) Bruenke, J., Roschke, I., Agarwal, S., Riemann, T. & Greiner, A. Quantitative comparison of the antimicrobial efficiency of leaching versus nonleaching polymer materials. Macromol. Biosci. 16, 647–654 (2016); (b) Mozaffari, E., Tanhaei, B., Khajenoori, M. & Khoshkho, S. M. Unveiling the swelling behavior of κ-carrageenan hydrogels: Influence of composition and physiological environment on drug delivery potential. J. Ind. Eng. Chem. 141, 217–227 (2024).
Ahmed, E. M. et al. Radiation synthesis of superabsorbent CMC based hydrogels for agriculture applications. Int. J. Biol. Macromol. 112, 1191–1198 (2018).
Li, Y. et al. ZnO-loaded polymeric hydrogels: Synthesis, characterization and antibacterial activity. Colloids Surf. B Biointerfaces 178, 460–467 (2019).
Zhang, H. et al. pH-responsive hydrogels with metal oxide nanoparticles for controlled drug delivery. J. Mater. Chem. B 6, 7312–7325 (2018).
Kumar, A. et al. Highly swellable and antibacterial hydrogels based on polysaccharides and synthetic polymers. Carbohydr. Polym. 275, 118696 (2022).
Rashidzadeh, A. et al. Structural and morphological evaluation of CMC-based hydrogels. Polym. Test. 78, 105972 (2019).
Emam, H. E. et al. Functionalization of medical cotton with ZnO nanoparticles via gamma radiation for antibacterial applications. Cellulose 27, 8401–8428 (2020).
Zadehnazari, A. Metal oxide/polymer nanocomposites: A review on recent advances in fabrication and applications. Polym.-Plast. Tech. Mater. 62, 655–700 (2022).
Acknowledgements
The researchers thank the Nuclear Science and Technology Research Institute (NSTRI) for supporting this study.
Author information
Authors and Affiliations
Contributions
Mahsa Radmehr: Investigation, Software, Writing an original draft.Ahmad Poursattar Marjani: Project administration, Supervision, Writing–review, and edition.Azam Akhavan: Project administration, Supervision, Writing–review, and edition.
Corresponding authors
Ethics declarations
Competing interests
The authors declare no competing interests.
Additional information
Publisher’s note
Springer Nature remains neutral with regard to jurisdictional claims in published maps and institutional affiliations.
Rights and permissions
Open Access This article is licensed under a Creative Commons Attribution-NonCommercial-NoDerivatives 4.0 International License, which permits any non-commercial use, sharing, distribution and reproduction in any medium or format, as long as you give appropriate credit to the original author(s) and the source, provide a link to the Creative Commons licence, and indicate if you modified the licensed material. You do not have permission under this licence to share adapted material derived from this article or parts of it. The images or other third party material in this article are included in the article’s Creative Commons licence, unless indicated otherwise in a credit line to the material. If material is not included in the article’s Creative Commons licence and your intended use is not permitted by statutory regulation or exceeds the permitted use, you will need to obtain permission directly from the copyright holder. To view a copy of this licence, visit http://creativecommons.org/licenses/by-nc-nd/4.0/.
About this article
Cite this article
Radmehr, M., Poursattar Marjani, A. & Akhavan, A. Synthesis and characterization of antibacterial CMC/AAc/ZnO nanocomposite superabsorbent using gamma radiation. Sci Rep 15, 9345 (2025). https://doi.org/10.1038/s41598-025-93884-8
Received:
Accepted:
Published:
Version of record:
DOI: https://doi.org/10.1038/s41598-025-93884-8